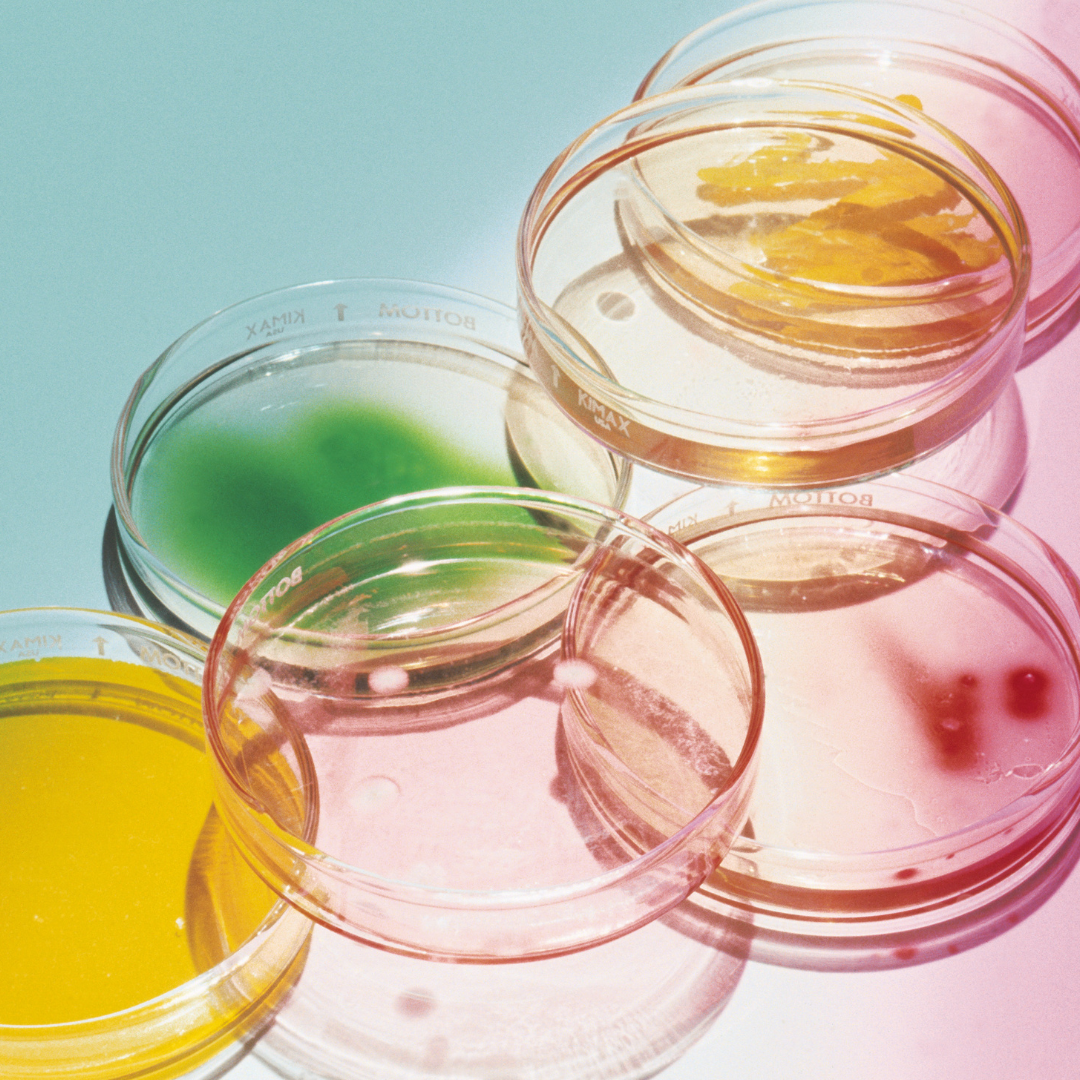

All-in-one Sanitizer, Serum & Moisturizer
Enjoy a luxurious hand spa in a bottle with this Skin Saviour!
Formulated to respect the most delicate skin types and
provide you with soft, tender moments throughout your day.
Dream Hand Mist
Leave your skin velvety smooth with our Dream Hand Mists that will ensure your hands stay clean and moisturized all day. A hand sanitizer that eliminates all of the unpleasant factors of sanitizing (such as: strong “tequila” smell and sticky, drying feeling). Fall in love with hands that are soft to the touch and smell good too.
this was made for you* 70% Ethyl Alcohol
Food grade ethyl alcohol derived from sugarcane that kills 99.9% of germs without the impurities that irritate sensitive skin and lead to heavy alcohol odors.
* Saccharide Isomerate
A 100% plant-derived carbohydrate complex known for its excellent ability to bind to skin. This vegan hyaluronic acid booster delivers instant and long-lasting hydration for up to 72 hours. *Reduces unwanted effects of skin dryness with a strong cumulative moisture recovery effect even after daily washing!
* CICA
Anti-inflammatory, anti-bacterial, and infused with antioxidants to help protect and repair your skin's natural barrier. Centella Asiatica works on soothing inflamed skin while preventing moisture loss, increasing collagen production, and restoring your skin's hydration levels.
* Niacinamide
Vitamin B3 - a skin-restoring hero that’s great for all skin types. Renews and restores the skin from moisture loss and dehydration by helping improve its natural production of skin-strengthening ceramides. Used regularly, it also helps skin appear smoother, more radiant, and even-toned.
* Vitamin E
An effective moisturizing agent that not only improves the elasticity and smoothness of the skin but also helps defend from pollution and other environmental stressors.